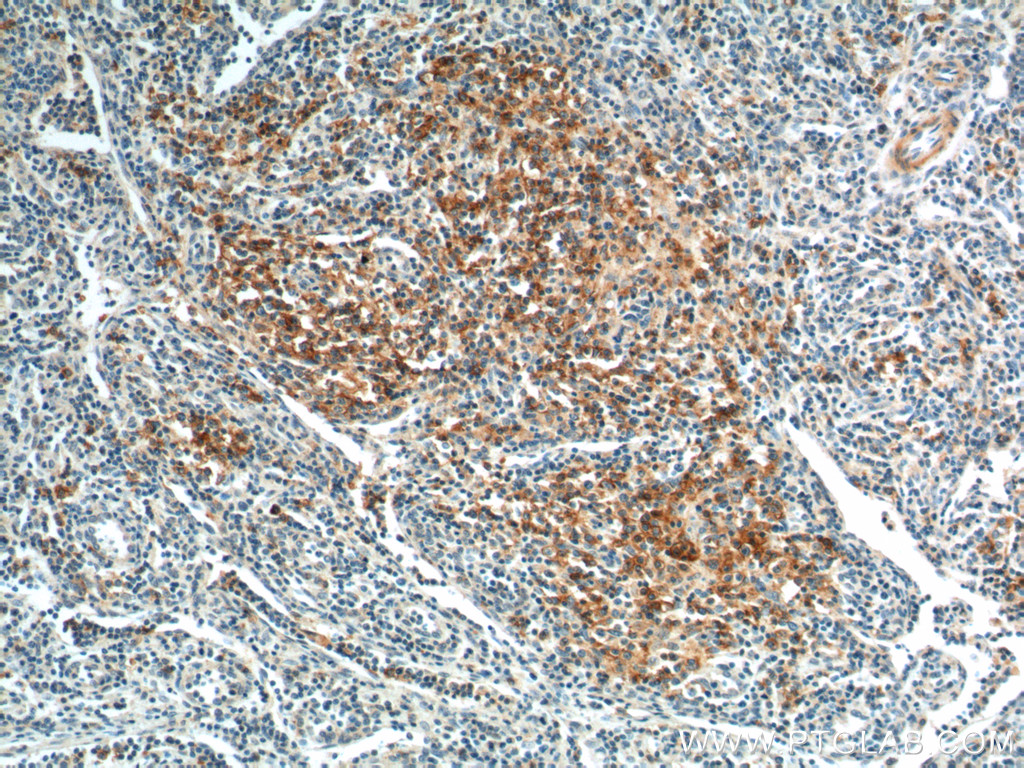

验证数据展示
经过测试的应用
| Positive IHC detected in | human tonsillitis tissue, human lymphoma tissue Note: suggested antigen retrieval with TE buffer pH 9.0; (*) Alternatively, antigen retrieval may be performed with citrate buffer pH 6.0 |
| Positive IF-P detected in | human tonsillitis tissue |
推荐稀释比
| 应用 | 推荐稀释比 |
|---|---|
| Immunohistochemistry (IHC) | IHC : 1:500-1:2000 |
| Immunofluorescence (IF)-P | IF-P : 1:50-1:500 |
| It is recommended that this reagent should be titrated in each testing system to obtain optimal results. | |
| Sample-dependent, Check data in validation data gallery. | |
产品信息
18106-1-AP targets PD-1/CD279 in IHC, IF-P, IP, CoIP, ELISA applications and shows reactivity with human samples.
| 经测试应用 | IHC, IF-P, ELISA Application Description |
| 文献引用应用 | IHC, IF, IP, CoIP |
| 经测试反应性 | human |
| 文献引用反应性 | human |
| 免疫原 |
CatNo: Ag12470 Product name: Recombinant human PD-1/CD279 protein Source: e coli.-derived, PET28a Tag: 6*His Domain: 1-288 aa of BC074740 Sequence: MQIPQAPWPVVWAVLQLGWRPGWFLDSPDRPWNPPTFSPALLVVTEGDNATFTCSFSNTSESFVLNWYRMSPSNQTDKLAAFPEDRSQPGQDCRFRVTQLPNGRDFHMSVVRARRNDSGTYLCGAISLAPKAQIKESLRAELRVTERRAEVPTAHPSPSPRPAGQFQTLVVGVVGGLLGSLVLLVWVLAVICSRAARGTIGARRTGQPLKEDPSAVPVFSVDYGELDFQWREKTPEPPVPCVPEQTEYATIVFPSGMGTSSPARRGSADGPRSAQPLRPEDGHCSWPL 种属同源性预测 |
| 宿主/亚型 | Rabbit / IgG |
| 抗体类别 | Polyclonal |
| 产品类型 | Antibody |
| 全称 | programmed cell death 1 |
| 别名 | CD279, PD1, PD-1, PD 1, hPD-1 |
| 计算分子量 | 288 aa, 32 kDa |
| GenBank蛋白编号 | BC074740 |
| 基因名称 | PD-1 |
| Gene ID (NCBI) | 5133 |
| RRID | AB_10732952 |
| 偶联类型 | Unconjugated |
| 形式 | Liquid |
| 纯化方式 | Antigen affinity purification |
| UNIPROT ID | Q15116 |
| 储存缓冲液 | PBS with 0.02% sodium azide and 50% glycerol, pH 7.3. |
| 储存条件 | Store at -20°C. Stable for one year after shipment. Aliquoting is unnecessary for -20oC storage. |
背景介绍
Programmed cell death 1 (PD-1, also known as CD279) is an immunoinhibitory receptor that belongs to the CD28/CTLA-4 subfamily of the Ig superfamily. It is a 288 amino acid (aa) type I transmembrane protein composed of one Ig superfamily domain, a stalk, a transmembrane domain, and an intracellular domain containing an immunoreceptor tyrosine-based inhibitory motif (ITIM) as well as an immunoreceptor tyrosine-based switch motif (ITSM) (PMID: 18173375). PD-1 is expressed during thymic development and is induced in a variety of hematopoietic cells in the periphery by antigen receptor signaling and cytokines (PMID: 20636820). Engagement of PD-1 by its ligands PD-L1 or PD-L2 transduces a signal that inhibits T-cell proliferation, cytokine production, and cytolytic function (PMID: 19426218). It is critical for the regulation of T cell function during immunity and tolerance. Blockade of PD-1 can overcome immune resistance and also has been shown to have antitumor activity (PMID: 22658127; 23169436). It has been reported that PD-1 is heavily glycosylated and migrates with an apparent molecular mass of 47-55 kDa on SDS-PAGE , which is larger than its predicted mass of 32 kDa (PMID: 8671665; 17640856; 17003438).
实验方案
| Product Specific Protocols | |
|---|---|
| IF protocol for PD-1/CD279 antibody 18106-1-AP | Download protocol |
| IHC protocol for PD-1/CD279 antibody 18106-1-AP | Download protocol |
| Standard Protocols | |
|---|---|
| Click here to view our Standard Protocols |
发表文章
| Species | Application | Title |
|---|---|---|
Nat Commun ERK and USP5 govern PD-1 homeostasis via deubiquitination to modulate tumor immunotherapy | ||
Adv Sci (Weinh) Targeting Deltex E3 Ubiquitin Ligase 2 Inhibits Tumor-associated Neutrophils and Sensitizes Hepatocellular Carcinoma Cells to Immunotherapy | ||
Sci Adv Promoting the activation of T cells with glycopolymer-modified dendritic cells by enhancing cell interactions. | ||
J Nanobiotechnology Oxygen-delivery nanoparticles enhanced immunotherapy efficacy monitored by granzyme B PET imaging in malignant tumors | ||
J Immunother Cancer Helicobacter pylori infection disturbs the tumor immune microenvironment and is associated with a discrepant prognosis in gastric de novo diffuse large B-cell lymphoma. | ||
Mol Ther PD-1/PD-L1 blockade is a potent adjuvant in treatment of Staphylococcus aureus osteomyelitis in mice |